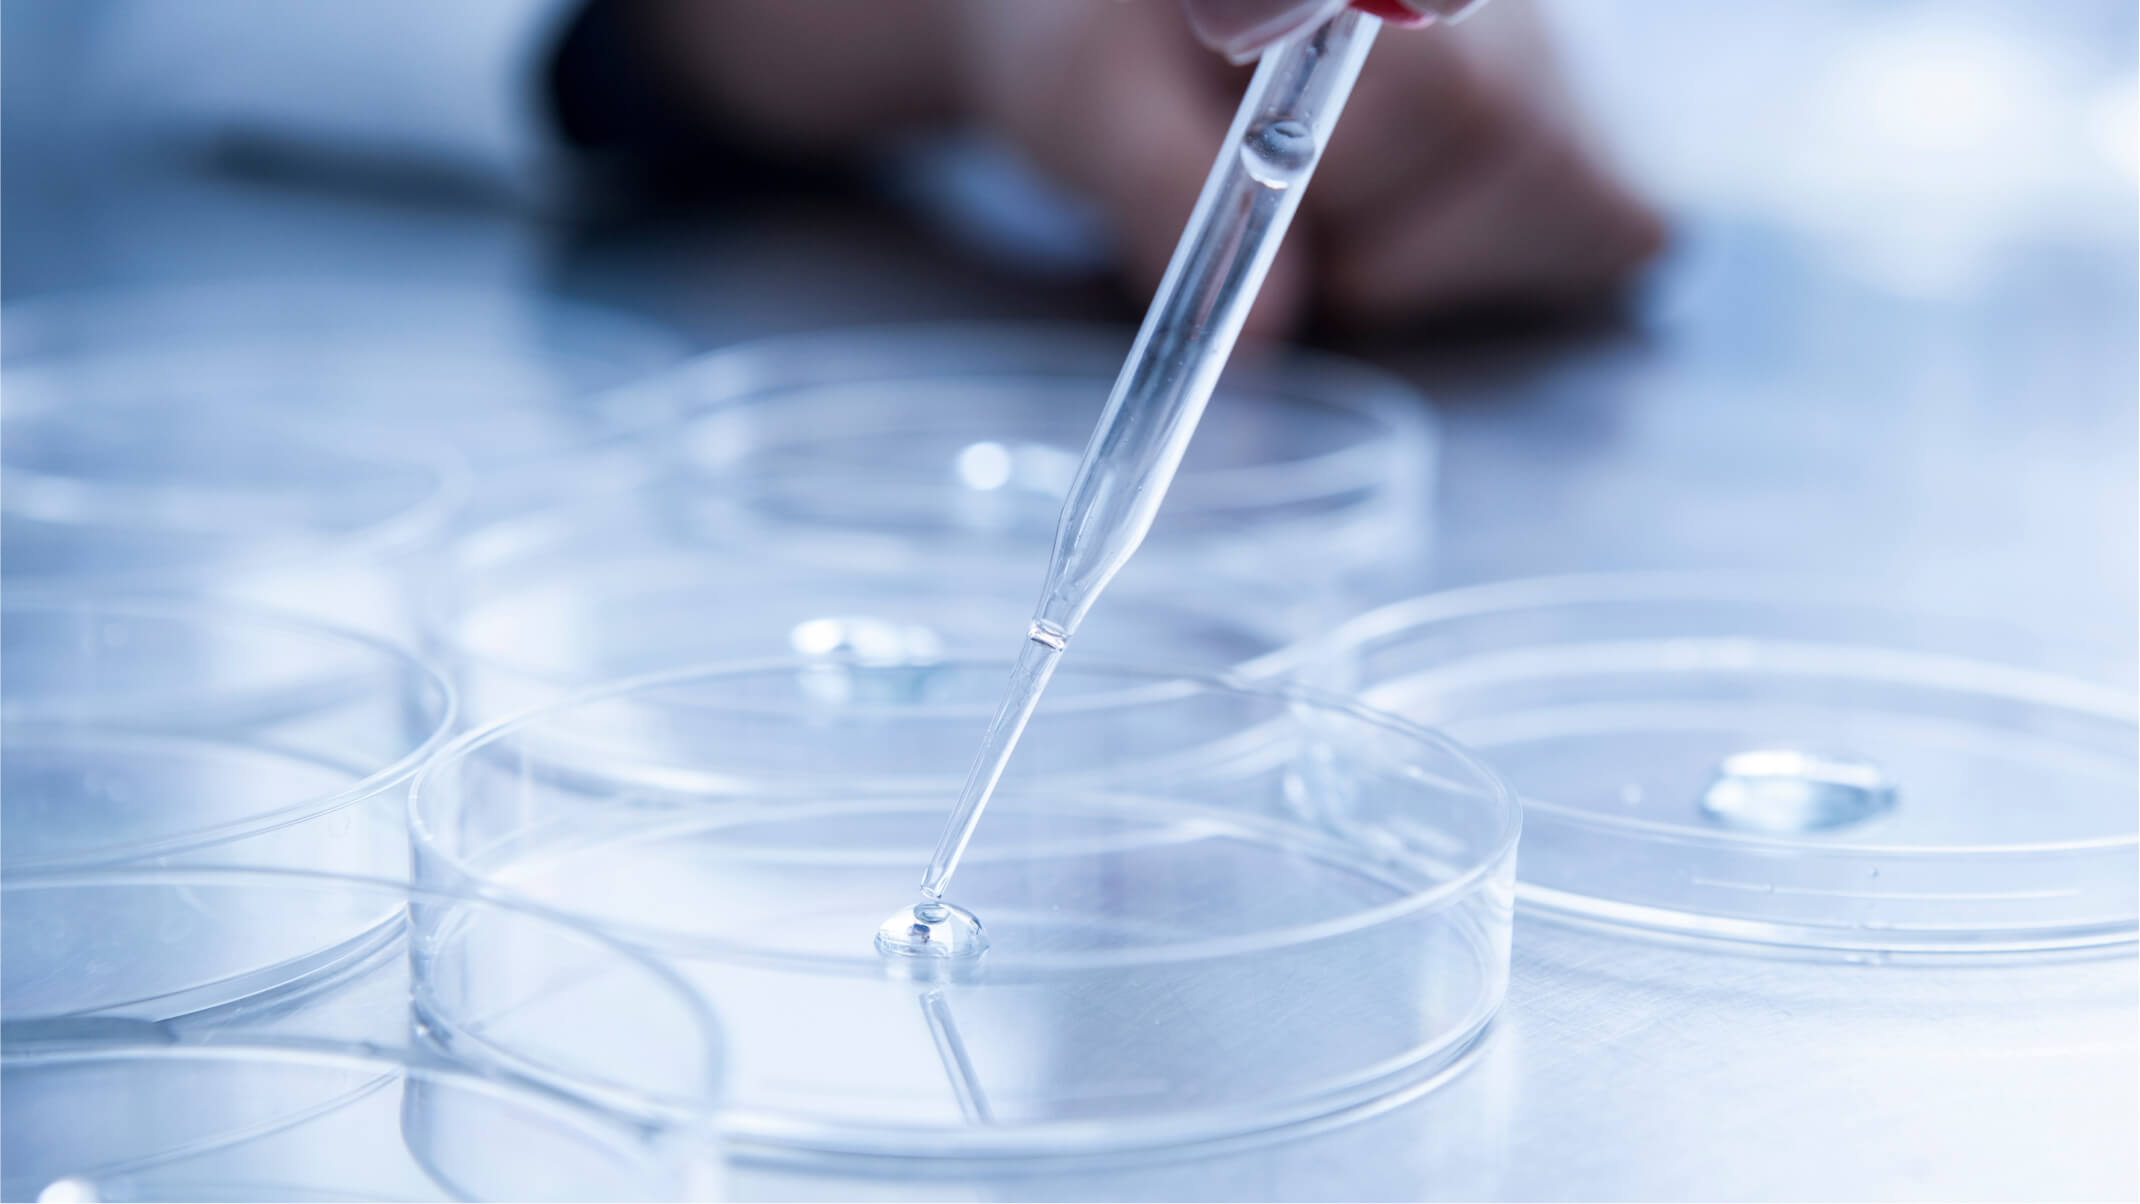
lanr subventionne dynveo pour ses recherches sur la biofermentation

La recherche au cœur de notre ADN
Chez Dynveo, la R&D repose sur une démarche scientifique structurée, guidée par les niveaux de maturité technologique (TRL) et par la maîtrise d’outils avancés comme la biofermentation. Notre laboratoire a été conçu pour internaliser l’ensemble du cycle d’innovation : formulation rationnelle, optimisation des procédés biologiques, montée en échelle et validation analytique. Chaque nouvel actif passe ainsi par une progression rigoureuse — de l’hypothèse initiale (TRL 1–2) jusqu’à la preuve de concept (TRL 3–5), puis à l’industrialisation maîtrisée (TRL 6–9). Cette approche nous permet de développer des ingrédients à haute valeur scientifique, parfaitement traçables, et dont l’efficacité repose sur une compréhension fine des mécanismes cellulaires. Ici, l’innovation n’est pas déclarative : elle est mesurée, documentée et reproductible.
Pipeline R&D
- TRL 1
- TRL 2
- TRL 3
- TRL 4
- TRL 5
-
Projet PAB
60% TRL 3
TRL 3 -
Projet GRISS
70% TRL4
TRL 4 -
Projet CCM
15% TRL 3
TRL 2 -
Projet BIOF-75
90% TRL4 -5
TRL 3 -
BIOCA-75
90% TRL5
TRL 3 -
Projet AXONE
90% TRL3- 4
TRL 3 -
Projet C-LLR31
90% TRL3- 4
TRL 3
01 TRL 1
02 TRL 2
03 TRL 3
04 TRL 4
05 TRL 5
Depuis 2010, Dynveo développe son activité de R&D et investit dans la recherche française avec les plus prestigieuses institutions comme partenaires.
En 2025, notre comité scientifique a consolidé ses avancées avec des résultats mesurables. Les pourcentages illustrent la progression de nos projets, l'élargissement de nos partenariats et l'impact croissant de nos recherches.
Ce bilan reflète rigueur, innovation et engagement collectif, tout en préparant de nouvelles perspectives ambitieuses pour les années à venir.
Nous affirmons également notre volonté d'intensifier la collaboration internationale, de renforcer la diffusion des savoirs et de favoriser l'émergence d'initiatives novatrices, afin de prolonger cette dynamique positive.
Définition des TRL
La R&D chez Dynveo en quelques chiffres
"Quand j’ai fondé Dynveo, je ne voulais pas créer une marque de plus. Je voulais ouvrir une nouvelle voie. Pour cela, il fallait investir là où tout commence : dans la recherche. C’est en développant les actifs de demain que nous pouvons véritablement faire évoluer les standards du marché et offrir une nutraceutique plus juste, plus pure, plus exigeante."
"Notre mission en R&D est simple : transformer des hypothèses biologiques en preuves tangibles. Chaque projet que nous développons doit démontrer, chiffres à l’appui, qu’il apporte une vraie valeur fonctionnelle."
"La recherche chez Dynveo n’est pas un département : c’est l’ADN même de l’entreprise. Cette culture scientifique attire naturellement des talents qui veulent contribuer à des projets ambitieux, techniquement exigeants dans un environnement où la recherche est centrale."
15
Années de recherche
pour formuler les compléments les plus purs du marché et mettre au points les actifs de demain.
6
Projets de recherche en cours
en partenariat avec les plus prestigieuses institutions.
10%
du chiffre d'affaires
investis chaque année dans nos projets R&D, en collaboration avec des laboratoires de recherche publics et privés européens de 1er plan.
+15
experts & scientifiques
internes et indépendants interviennent au quotidien dans le pilotage des projets de recherche et développement.
Un comité scientifique qui éclaire notre vision de la santé de demain
Comité scientifique

Pauline Beaumont
Fonction
Comité scientifique

Pr Jean-Marie François
Fonction
Projets
Depuis 5 ans, il conseille la société Dynveo sur des projets de biotechnologies, dont un projet de production de glycine par fermentation financé par l'ANR.
Etudes
Expert en microbiologie industrielle qui obtient son doctorat en sciences agronomiques en 1988. Il poursuit par des stages postdoctoraux aux États-Unis puis est tour à tour chargé de cours à l’Université de Bordeaux, de Paris-Jussieu et de Louvain la Neuve. En 1993, il est nommé Professeur à l'INSA de Toulouse où il fonde une équipe de recherche en biotechnologie industrielle. Avec plus de 230 publications et 30 brevets à son actif, il est largement reconnu par la communauté scientifique. Il a joué un rôle clé dans la création de la Génopole de Toulouse et dans des projets R&D, comme celui de la production biologique de méthionine avec la société Adisseo. Il a également participé à la fondation et assuré le rôle de conseiller scientifique de deux sociétés dans le domaines de Nanobiotechnologie entre les année 2010 et 2024
Comité scientifique

Pr Maria Inês RE
Fonction
Projets
Elle pilote une thèse en collaboration avec Dynveo, portant sur les mélanges multi-constituants de poudres bioactives.
Etudes
Experte en génération, caractérisation et mise en forme de particules solides multi-composants pour la santé. Professeure et directrice adjointe du centre RAPSODEE UMR 5302, elle est responsable scientifique de la plateforme Gala®. Forte d'une carrière de recherche à IMT Mines Albi et à l'IPT à São Paulo, elle a dirigé de nombreuses thèses et projets de recherche en génie des procédés et matériaux. Elle a contribué à des avancées significatives, avec 56 publications et 4 brevets, et a été reconnue parmi les 2 % de scientifiques les plus influents par la liste Stanford/Elsevier en 2023 et 2024.
Comité scientifique

Pr Agnès COSTE
Fonction
Projets
Très impliquée dans le milieu industriel, elle collabore depuis plusieurs années à des thèses CIFRE, notamment avec Dynveo, dans le domaine de la nutraceutique.
Etudes
Experte dans l'étude du rôle des cellules myéloïdes et des cellules stromales mésenchymateuses ainsi que leurs interactions, notamment dans le contexte de l'inflammation chronique liée au vieillissement (inflammaging) et les pathologies associées. Elle dirige l'équipe FLAMES au sein de l'UMR RESTORE (UT3/INSERM/CNRS/EFS/ENVT) et a contribué à plus de 60 publications et brevets. Ses recherches visent à comprendre et moduler les mécanismes inflammatoires et oxydants pour améliorer la résolution de l'inflammation et la réparation tissulaire.
Comité scientifique

Victorine Douin-Echinard
Fonction
Projets
Victorine Douin-Echinard est professeure des universités en physiologie et chercheuse reconnue pour ses travaux en biomédecine, notamment sur les mécanismes d’inflammation, le vieillissement cellulaire et les interactions entre microenvironnement stromal et fonctions métaboliques. Elle exerce à l’Université Toulouse III – Paul Sabatier, où elle est impliquée dans l’équipe RESTORE du laboratoire associé à l’INSERM et au CNRS, axée sur la physiopathologie des processus inflammatoires liés à l’âge. Sa production scientifique couvre des contributions importantes à la compréhension de la sénescence cellulaire, de l’inflammaging et des régulations immunitaires, avec de nombreuses publications dans des revues internationales. Ces expertises fondamentales l’ont amenée à rejoindre le comité scientifique de Dynveo, contribuant à l’orientation rigoureuse des travaux de recherche et au développement d’approches nutraceutiques validées scientifiquement
Comité scientifique

Dr Nicolas Dedieu
Fonction
Projets
Fort de plus de vingt ans d’expérience en pharmacie, il a orienté sa pratique vers l’analyse des mécanismes physiopathologiques impliqués dans les pathologies chroniques.
Son expertise porte principalement sur la santé digestive et le microbiote, et les dysfonctionnements mitochondriaux, considérés comme des axes centraux du terrain métabolique moderne.
Etudes
Sa démarche repose sur l’analyse biologique fonctionnelle, l’interprétation systémique des axes physiologiques et une approche intégrative associant micronutrition, phyto-aromathérapie et modulation du microbiote.
Il est également Secrétaire général du SYNAMIEF (Syndicat National de Médecine Intégrative et Fonctionnelle).
Nous collaborons avec les institutions les plus prestigieuses et rigoureuses
Foire aux questions
Nous travaillons avec des partenaires académiques et industriels de référence pour renforcer la rigueur scientifique, accélérer l’innovation et garantir la qualité de nos actifs à chaque étape de développement.
Le CIRAD apporte son expertise en agronomie et valorisation des bioressources naturelles, nous permettant d’identifier et d’exploiter des matières premières durables et innovantes.
Ils nous permettent de rester à la pointe de la recherche, d’anticiper les évolutions du secteur nutraceutique et de proposer des solutions scientifiquement validées pour la santé intégrative.
La durée d’un projet varie selon sa complexité, mais en moyenne, un cycle complet, de la conception à la mise en production, s’étend sur 2 à 5 ans. Nous espérons présenter nos premiers actifs brevetés Dynveo dans les prochaines années.
Le comité scientifique supervise nos orientations de recherche, valide les méthodologies, évalue les résultats et garantit que toutes nos innovations respectent les standards les plus élevés en matière de rigueur scientifique et d’éthique.